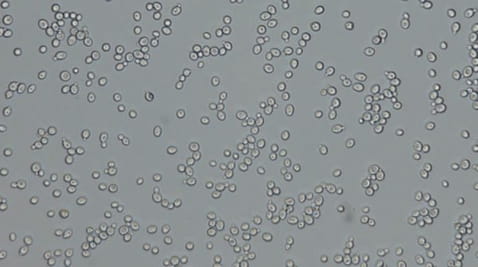

Переваги підписки SWEET.TV
 Фільми без реклами
Фільми без реклами
 Висока якість зображення
Висока якість зображення
 Пауза/перемотування прямого ефіру
Пауза/перемотування прямого ефіру
 Підключай 5 пристроїв
Підключай 5 пристроїв
Читати далі
Аудіодоріжки:
Дивись на всіх пристроях
Акторський склад

Невідомий
Актор Продюсер
Невідомий
 Скопіювати посилання на фільм
Скопіювати посилання на фільм